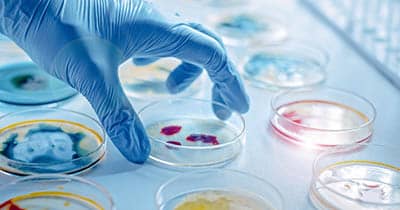

Actuele onderwerpen

In Vitro Diagnostics Regulation (IVDR)
Sinds 26 mei 2022 is de In Vitro Diagnostics Regulation 2017/746 (IVDR) van toepassing met specifieke regels voor de indiening, beoordeling en uitvoering van prestatiestudies naar in-vitro diagnostica.
Lees verder
Clinical Trial Regulation (CTR)
Sinds 31 januari 2022 is de Clinical Trial Regulation 536/2014 (CTR) van toepassing met nieuwe regels voor geneesmiddelenonderzoek in de Europese Unie. Vanaf 31 januari 2023 worden alle nieuwe aanvragen voor geneesmiddelenonderzoek via CTIS ingediend.
Lees verder
Medical Device Regulation (MDR)
Sinds 26 mei 2021 is de Medical Device Regulation 2017/745 (MDR) van toepassing met specifieke regels voor de indiening, beoordeling en uitvoering van klinisch onderzoek naar medische hulpmiddelen.
Lees verder
Nieuws
CCMO beperkt bereikbaar rond de feestdagen
Van maandag 22 december 2025 tot en met vrijdag 2 januari 2026 is de CCMO beperkt bereikbaar. Het kantoor is in die periode ...
Lees verderAangepaste versie van model protocol CTR-studies gepubliceerd
Vandaag, 11 november 2025, heeft de CCMO een aangepaste versie gepubliceerd van het model protocol voor CTR-studies. Het wordt ...
Lees verder
Nieuwe voorzitter Michaël Boele van Hensbroek wil evenwichtiger werkverdeling in commissie
Op 1 juli van dit jaar volgde Michaël Boele van Hensbroek Joop van Gerven op als voorzitter van de Centrale Commissie ...
Lees verderCommittee finder en andere tools niet meer beschikbaar
Met ingang van 1 oktober 2025 zijn de committee finder, de clinical trial decision tool en de e-learning clinical research niet ...
Lees verderInformatie over etikettering verbeterd
De tekst over etikettering van onderzoeksgeneesmiddelen op de CCMO-website is vernieuwd.
Lees verderE-mailattenderingen CCMO.nl stopgezet
Gebruikers van de CCMO-website kunnen nu nog gebruikmaken van e-mailattenderingen. Wie deze heeft ingeschakeld ontvangt een ...
Lees verder
